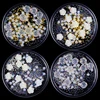
Изображение товара 5

Набор ювелирных украшений AB Bows Стразы для творчества, летние украшения, смешанные жемчужные кристаллы, подвески для ногтей, милые аксессуары 




120,84₽
Промокод: HGQO884P3X73 получите скидку 5₽ на заказ от 377.72₽
В наличии!
Nail Designs Factory Store - Надежность 95.25%
Более 17319 подписчиков, дата открытия магазина 28.11.2017
- Положительные оценки: 97% (4159)
- Соответствие описанию: 96%
- Отвечает на сообщения: 96%
- Скорость отправки: 92%
Последнее обновление: 18.05.2022